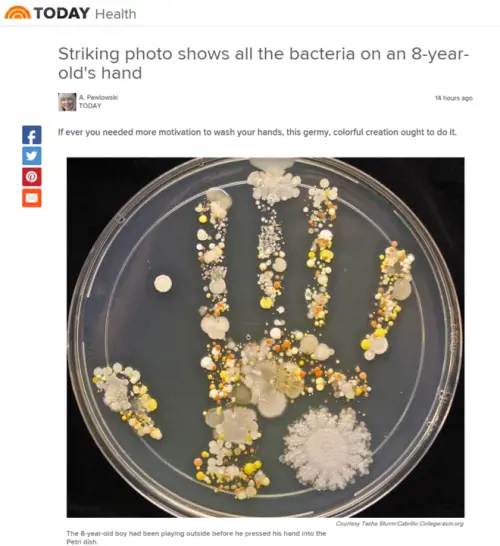
Quanti microbi ci sono sulla mano di un bambino

I microorganismi sono un trilione e solo pochi ci danneggiano. Gli studiosi: "Sono fondamentali per la vita: proteggiamoli"

I microorganismi sono un trilione e solo pochi ci danneggiano. Gli studiosi: "Sono fondamentali per la vita: proteggiamoli"

Secondo uno studio pubblicato su Nature i surrogati della carne ottenuti con le proteine microbiche possono contribuire a ridurre la deforestazione e le emissioni di gas serra. Ma non sono chiari gli effetti sulla salute umana

Oltre al problema igienico, la struttura ospedaliera soffre la cronica carenza di personale, in particolare degli infermieri

L'allarme dell'Onu: "La situazione sanitaria ed economica precipiterà entro il 2030. I leader della terra devono agire"

Scoperto un batterio resistente alla colistina, l'antibiotico superpotente. Gli scienziati: "Scoperta particolarmente allarmante"

Una ricerca scientifica di un'università di New York ha dimostrato che le tastiere dei bancomat, essendo ricche di batteri, funghi e residui di cibo, favoriscono la diffusione dell'influenza stagionale

L'esperimento di una mamma: "Ecco perché bisogna mantenere in salute il nostro sistema umanitario"